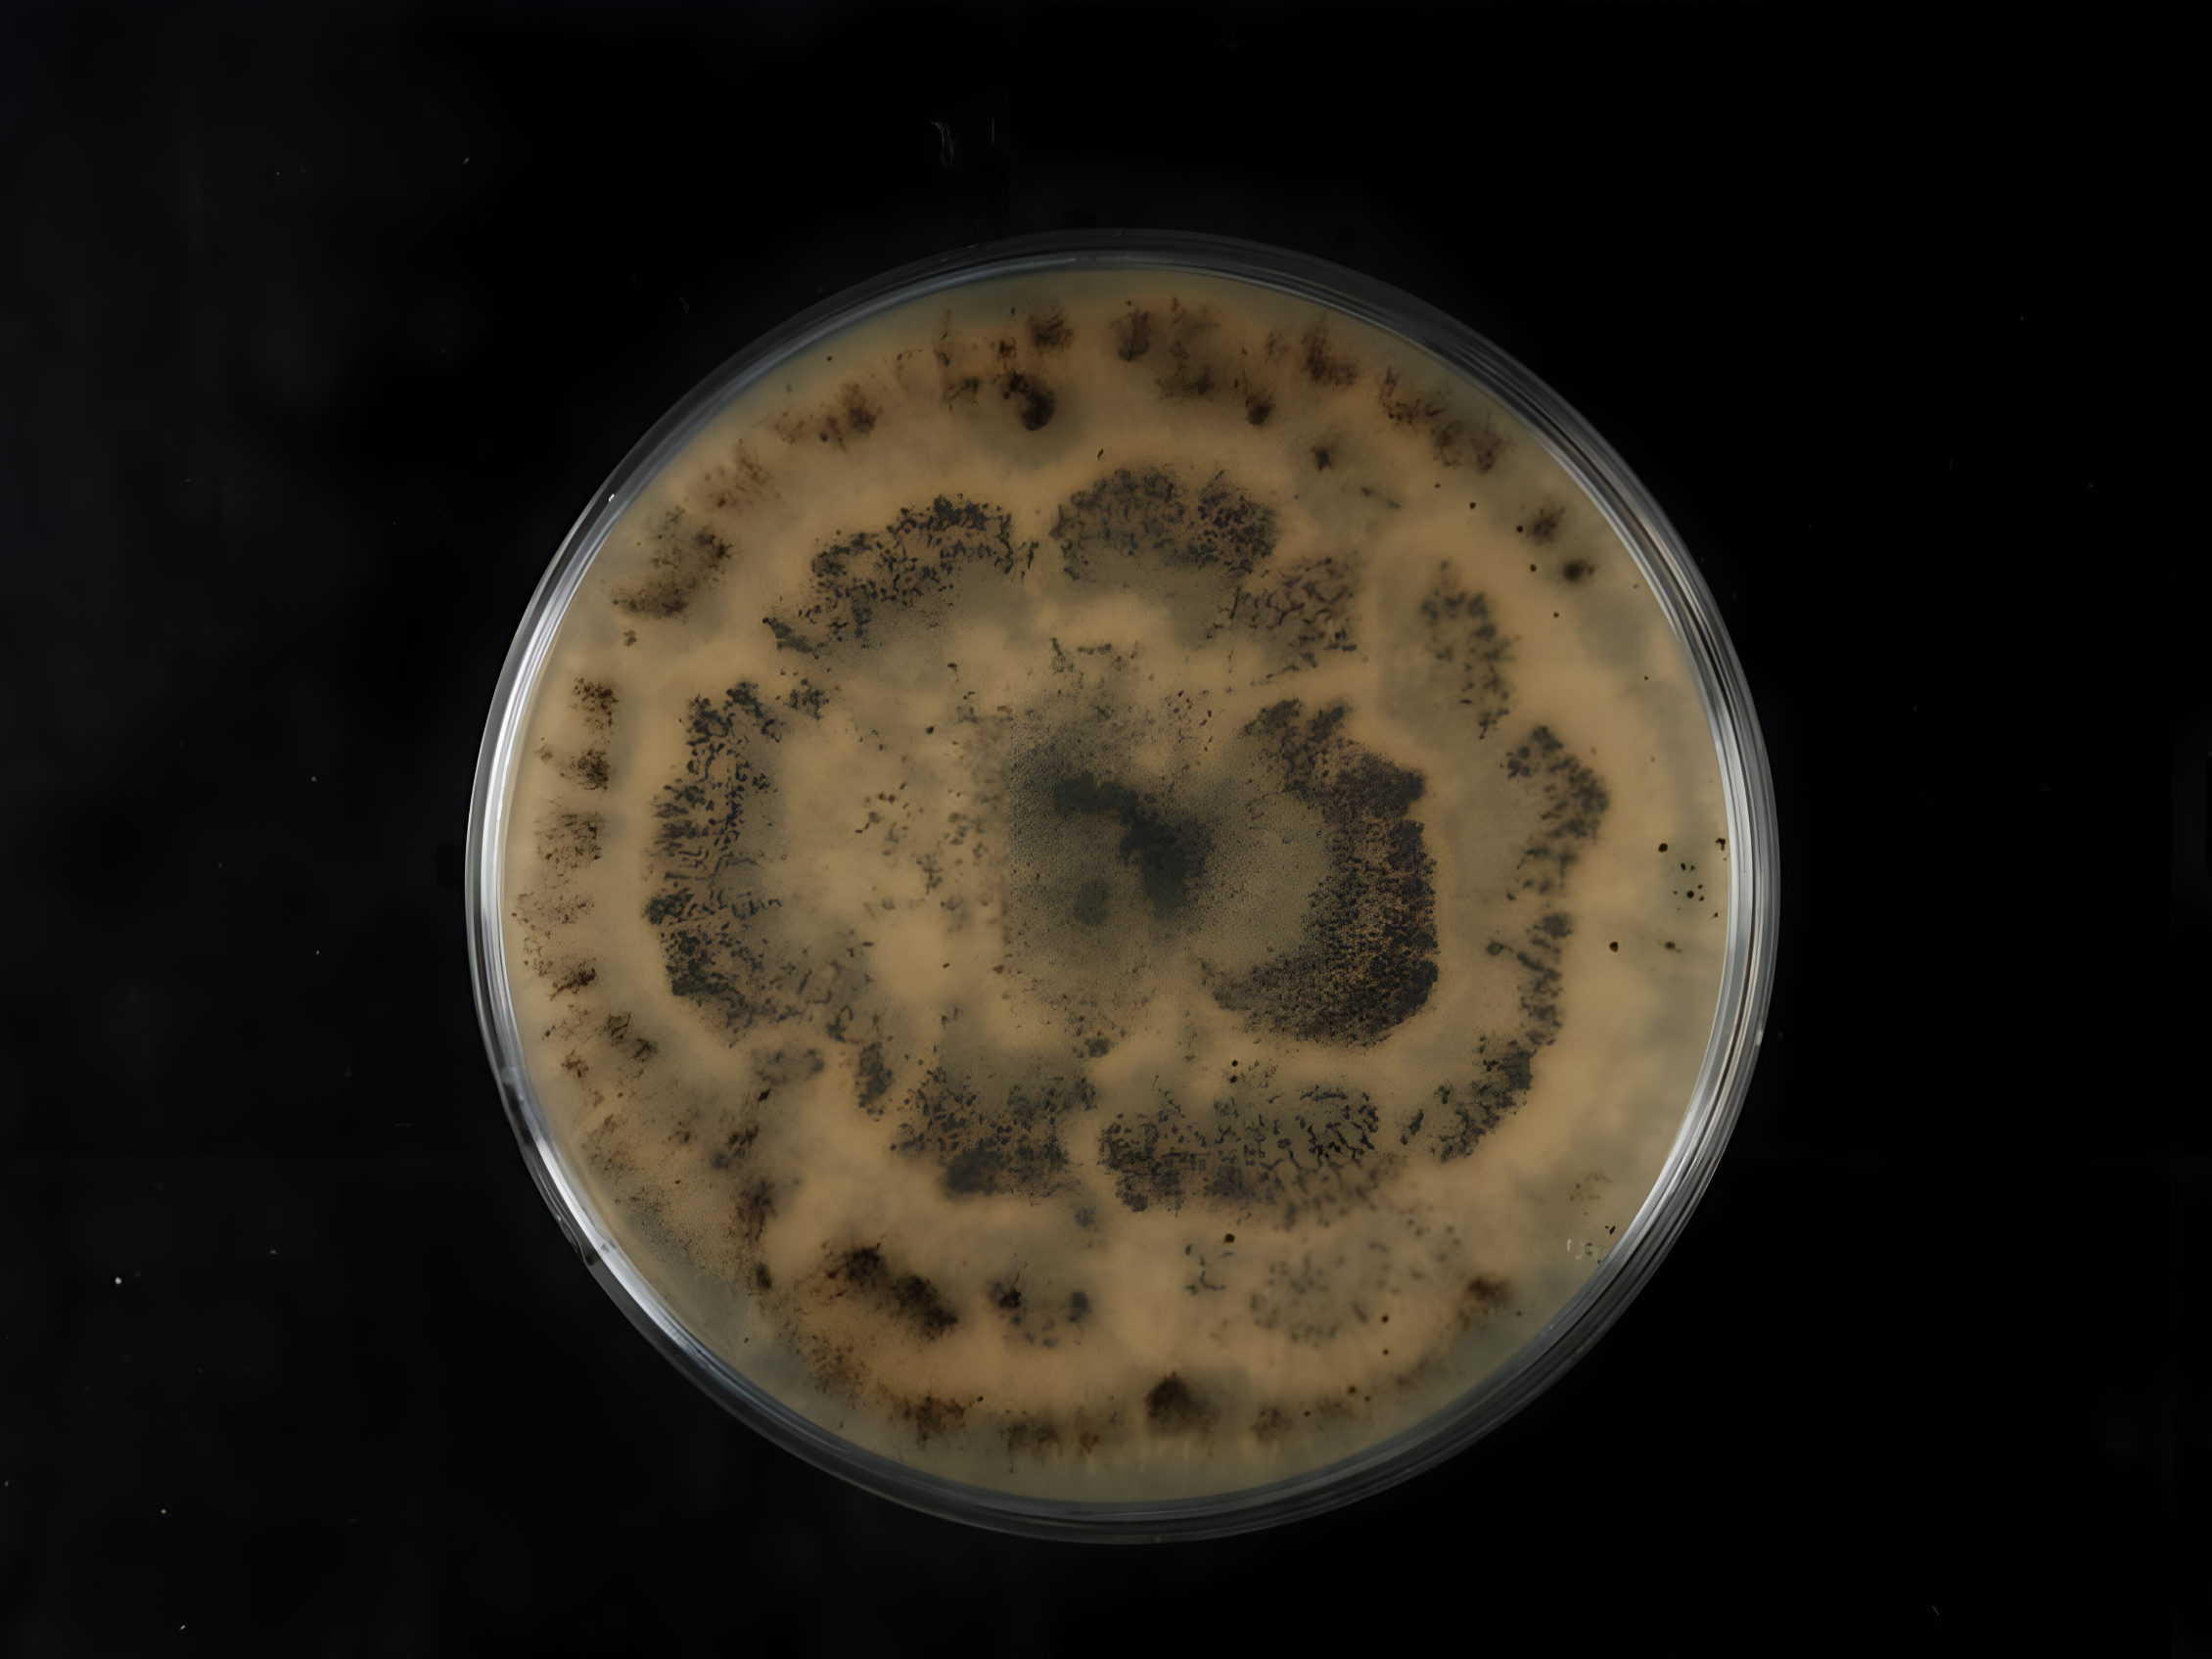

Nature’s plastic solution, hidden in the Amazon
Clouds weave through lush Amazonian mountains, highlighting the rainforest’s rich biodiversity and the hidden microbial life that thrive in these humid, ancient ecosystems.
Beneath the noise
Before fact hardens into form, before we name what we barely understand, there is the tremor of realization that a quiet marvel has been at work in the underplaces. It moves with the patience of rain carving stone, with the insistence of roots seeking depth. Hidden in soil and in the small rooms inside plants, in the quiet rot of old wood — and now, remarkably, in the plastic waste we leave behind.
We have long imagined plastic as immutable, a material that outlives us and our grandchildren, a near-geological imprint of human excess. But from the depths of tropical soils and the folds of Amazonian plant tissues comes a revelation that reads like myth: a fungus capable of eating plastic. Not merely softening it, not merely weathering it — devouring it, dismantling it into molecules simple enough to sustain life.
Yet the story begins not in the forest, but in the flood of plastic that has come to define the Anthropocene. Each day, oceans, rivers, and lakes receive an astonishing amount of plastic—equivalent to the contents of 2,000 garbage trucks (UNEP, 2025). Between 19 and 23 million tonnes of plastic enter waterways annually, smothering ecosystems and threatening livelihoods, food security, and the health of millions worldwide.
Used glass bottles, beer cans, and plastic debris lying on dry soil, revealing the everyday waste that accumulates unnoticed and harms local ecosystems, wildlife, and soil quality.
Once hailed as miraculous — light, cheap, versatile — plastics have become an omnipresent shadow. From medical devices to spacecraft, from food packaging to protective helmets, our civilization owes much to these materials. Yet nearly half of all plastic produced today is single-use. These fleeting conveniences can persist for centuries (Parker, 2023; Sharp & Kar, 2024). Microplastics now float in the water we drink, the air we breathe, and even in the placenta and breastmilk of newborns (Smith, 2025; Sharp & Kar, 2024). Animals are ensnared and poisoned; coral reefs suffocate under fragments; birds, elephants, whales, and zebras mistake plastic for food, with lethal consequences (Morunga, 2024; Yeoman, 2019).
The scale is staggering. Since 1950, global production has surged from 2 million tonnes to over 450 million tonnes annually (Ritchie, Samborska & Roser, 2023). Landfills, oceans, and rivers are choked; microplastics infiltrate even the most remote corners, from the Himalayas to the Mariana Trench (Yeoman, 2019; Parker, 2023). Efforts at recycling or biodegradable alternatives offer only partial relief. Most “biodegradable” plastics fail outside controlled conditions, leaving the persistent polymers to fragment into nanoplastics that continue to circulate through ecosystems (Afshar et al., 2024; Sustainability Directory, 2025).
Even economically, the cost is enormous: governments spend roughly $1.5 trillion annually managing health impacts, environmental cleanup, and waste processing, while the plastics themselves continue to accumulate (Smith, 2025). Projections suggest production could triple by 2060, pushing the crisis from inevitable to catastrophic (Smith, 2025; Ritchie et al., 2023).
Yet, amid this maelstrom, a whisper of hope emerges…
The forest and the hidden engineers
In the humid tropics, the genus Pestalotiopsis has been living out its small, unnoticed life for millions of years. Maharachchikumbura et al. (2011) describe them as quiet inhabitants, tucked inside leaves or resting among detritus, their spores delicate as needlework, elegant in microscopic scale. Their diversity, once read through morphology alone, has deepened with molecular phylogenies: these organisms are more ancient, more intricate, and more adaptive than scientists once believed.
Yet their true marvel lies not in their taxonomy but in their metabolism. These fungi possess biochemical abilities vast and versatile — capable of transforming compounds even other fungi find unyielding. Among these capacities sits a talent suited uncannily to our time: some species can degrade polyurethane, one of the most notoriously durable plastics on Earth, and they can do so in environments almost entirely devoid of oxygen. A feat both natural and radical.
In 2011, researchers from Yale — wandering through Ecuador’s thick, ale-scented air — discovered what would become one of the most promising lines of inquiry in plastic bioremediation. As Russell et al. (2011) recount, they were studying endophytic fungi, organisms that live quietly inside plant tissues without causing harm. Their hypothesis was elegant: if these fungi can break down lignocellulose, one of nature’s toughest polymers, might they also be able to dismantle synthetic polymers like polyurethane?
The answer was not just yes — it was beyond yes.
Two slender mushrooms standing in soft green moss, echoing the invisible fungal networks that sustain forests and hint at the Amazon’s remarkable plastic-degrading endophytes — nature’s quiet engineers.
Nearly half of the fungi tested showed some ability to degrade PUR. And two strains of Pestalotiopsis microspora did something unprecedented: they could use polyurethane as their sole source of carbon, even under anaerobic conditions. This meant they could thrive in places where most organisms fail — places like soils starved of oxygen, marine debris mats, or the sealed chambers of landfills.
Moreover, they hold the enzymatic key to their own success: a serine hydrolase, a diffusible, extracellular enzyme able to break the polymer’s ester bonds in less than an hour. A quiet shockwave in the microbial world.
What were once invisible fungi became, in that moment, emergent actors in one of the most urgent ecological stories of our century.
The discovery promised a natural, radical approach to a human-made crisis — one that could operate where oxygen is scarce: landfills, ocean gyres, and submerged debris mats.
This revelation opened the door to applied research. From the Fungi Mutarium project exploring fungal bioremediation on Earth and potentially in space, to studies of Pleurotus ostreatus and other wood-decay fungi, scientists are beginning to imagine a world where nature itself might help rewrite the story of plastic. Yet the challenge remains vast: degradation rates depend not only on the fungus but on polymer chemistry, environmental conditions, and co-contaminants (Sustainability Directory, 2025; Afshar et al., 2024).
The plastic predator
Rodríguez-Vázquez et al. (2015) uncovered the mechanism behind this persistence — a serine hydrolase that drifted freely outside fungal cells, as if eager to meet the world. In their assays, the enzyme worked with unsettling speed, unfastening ester bonds as though it had been practicing for millennia. Perhaps it had. Evolution rarely wastes a trick.
The enzyme’s efficiency suggests an uncomfortable truth: the barrier between “natural” and “synthetic” is thinner than our terminology implies. Polyurethane’s backbone may be engineered, but to the fungus it echoes the ancient signatures of decaying wood. In that long evolutionary apprenticeship lies the explanation for their modern relevance. The abilities that now feel miraculous — polymer degradation, metabolic flexibility, tolerance for anaerobic spaces — were forged in ecological negotiations older than our species. What we call innovation is simply evolution remembering itself.
Top-down view of a fungus colonizing a petri dish, representing the mysterious “plastic predator” — a type of microorganism capable of breaking down stubborn plastics, such as the polyurethane-degrading fungus Pestalotiopsis microspora, and inspiring new biodegradation research. Credits to: Elsa Paderes. © Landcare Research.
Still, it would be false to imagine this discovery as a ready-made solution to the plastic crisis. Pestalotiopsis is no silver bullet; it is a signal fire at the edge of a vast, tangled problem.
Polyurethane in the real world is seldom pure. It arrives weathered, contaminated, riddled with additives that inhibit microbial activity. And fungi, for all their tenacity, are slow sculptors. Rodríguez-Vázquez et al. showed enzymatic degradation occurring in hours under ideal conditions, but outside the lab, time stretches differently. Soil chemistry intervenes. Temperature falters. Competitor microbes jostle for niche space.
Even so, the fact remains: the waste stream is not dead matter. It is becoming habitat. And the moment we recognize plastic as ecological — not inert, not outside life — we begin to see how the planet is already responding to our excess.
The potential of now
Scientists now experiment with fungal bioreactors, enzyme cocktails optimized through protein engineering, and landfill bioaugmentation. Each attempt reflects a desire not just to break plastics apart, but to reintegrate them into cycles that can bear their weight. There is humility in this shift: the recognition that technology must learn from biology rather than attempt to dominate it.
Polyurethane, once imagined as the final word in durability, begins to look more like a misplaced resource — something we constructed without knowing its second life. Pestalotiopsis hints at that second life.
But the fungus, for all its promise, does not absolve us of responsibility. If anything, it sharpens our awareness of how deeply entangled we are in the materials we discard. The fact that an organism from a remote Ecuadorian forest can digest our waste is not a triumph; it is evidence of how far our plastics have traveled, and how urgently nature improvises responses to our neglect.
Perhaps this is the true gift of the discovery: not merely the enzymatic potential, but the change in perspective it demands.
The forest is not passive scenery. It is an active workshop of experiments, adaptations, alliances — some visible, most hidden. Endophytes that live quietly inside plant tissues are not peripheral actors; they are metabolizing the world alongside us. When researchers sliced into Amazonian stems in search of diversity, they stumbled into a story that binds our refuse to ancient cycles of decay and renewal.
The lesson is almost ecological theology: nothing is ever truly thrown away. Life reclaims what it can, in ways that may unsettle us.
Nature’s counterstrike
Science is still mapping the potential. Experiments show that under anaerobic conditions — the same oxygen-starved environments that stifle most life — P. microspora thrives on polyurethane alone. Enzymes, secreted into the surrounding medium, cleave the polymer’s bonds with a precision that outmatches most industrial methods. And while the laboratory demonstrates possibility, the forest embodies proof: life has always evolved to solve impossible problems, long before humans could even conceive them.
Beyond the chemistry, there is the broader lesson: entanglement. Plastic is not just waste; it weaves through ecosystems, threading its way into species, soils, waters, and human bodies alike. Microplastics infiltrate rivers, lakes, and oceans. Animals consume it, humans ingest it, chemicals leach into soil and water, and yet, within this seemingly irredeemable tangle, life persists. Microbes, fungi, and even insects find ways to appropriate these threads, to turn them into nourishment, to integrate them into cycles of growth and decay (Maharachchikumbura et al., 2011).
It is a reminder that the Anthropocene is not just a story of destruction. It is also a narrative of adaptation, of ingenuity at scales both vast and microscopic. Plastic pollution is a crisis — it kills, suffocates, and poisons (Morunga, 2024; Smith, 2025). But in the Amazon, hidden in the tissues of plants and soil, there exists a quiet counterforce. A force that insists: nothing is ever truly wasted, and every substance, no matter how synthetic, is a potential participant in life’s unfolding.
And so, the forest offers more than hope. By observing these systems, by respecting the ingenuity encoded in millions of years of evolution, humanity may learn not just to clean up our mess, but to live in ways that do not create new ones. The lesson is subtle, almost theological: life, in its infinite permutations, will reclaim what we discard — and in doing so, it asks us to reconsider what it truly means to throw anything away.
From the forest to the world
The story of Amazonian fungi is not confined to the damp understory or the pages of scientific journals. It ripples outward, intersecting with rivers clogged with bottles, oceans swirling with microplastics, and cities struggling under the weight of single-use disposables. Humanity produces more than 450 million tons of plastic each year, a fraction of which is properly recycled (Ritchie, Samborska & Roser, 2023; Sharp & Kar, 2024). The rest accumulates in landfills, waterways, and the environment, releasing toxins and fragmenting into microplastics that permeate our food, water, and even our blood (Smith, 2025; Sharp & Kar, 2024).
Traditional recycling, long hailed as a solution, cannot keep pace with this deluge. Less than 10% of plastic ever produced is effectively recycled, and biodegradable plastics often fail to degrade in real-world conditions (Afshar et al., 2024; The Sustainability Directory, 2025). Even with the most sophisticated industrial composting, additives, and chemical treatments complicate the breakdown process. Meanwhile, wildlife suffers profoundly: turtles, whales, albatrosses, and countless other species mistake plastic for food or become entangled in it, with lethal consequences (Morunga, 2024; Yeoman, 2019).
Yet the fungi of the Amazon offer a glimpse of possibility. They are living laboratories, demonstrating that nature can reclaim even the most persistent synthetic polymers. In harnessing such organisms, humanity may finally begin to turn the tide — not by brute force, but by cooperation. Industrial-scale application of fungal biodegradation remains in its infancy, yet pilot studies suggest that enzymes secreted by these microbes could be used to break down polyurethane and other stubborn plastics more efficiently than mechanical or chemical methods.
The implications are enormous. Integrating fungal biodegradation into waste management could reduce the volume of plastics entering waterways, slow the formation of microplastics, and alleviate pressures on ecosystems already under siege from human activity (The National Caucus of Environmental Legislators, n.d.; UN Environment Programme, 2025). Coupled with policy measures — reducing single-use plastics, redesigning products for longevity and recyclability, and implementing circular economy frameworks — such biotechnological solutions could transform plastic from a permanent pollutant into a recoverable resource.
Plastic bags and fragments suspended in blue ocean water as fish swim among the debris — a powerful reminder that plastic pollution travels far beyond its source, infiltrating seas, wildlife, and the planet’s most remote ecosystems.
Pressure for change
Science alone cannot save the planet. Even with revolutionary discoveries like plastic-eating fungi, the responsibility to act rests squarely on human institutions: governments, corporations, and communities. Policies that limit single-use plastics, enforce strict recycling standards, and incentivize sustainable production are not optional; they are urgent. National and international commitments, from treaties to municipal regulations, must move beyond promises and pilot programs toward measurable results (UN Environment Programme, 2025; Smith, 2025).
Companies, too, bear a moral and ecological obligation. The petrochemical giants that fuel the plastic boom cannot simply pivot toward superficial “greenwashing” campaigns. Product design must consider end-of-life impacts, reducing chemical hazards and improving recyclability (Afshar et al., 2024; The Sustainability Directory, 2025). Investors and consumers are increasingly aware that profit without planetary responsibility is unsustainable — and pressure from these stakeholders can accelerate meaningful change.
The public engagement drives political and corporate action. Citizen advocacy, environmental activism, and grassroots campaigns — from river clean-ups to ocean expeditions tracking microplastics — create accountability. The story of the Amazonian fungi reminds us that nature has always been innovating, adapting, and repairing. But it cannot bear the full burden of our mistakes. We must push human systems to evolve at a similar pace, ensuring that science, policy, and culture work in tandem to safeguard the living world.
In the end, the Amazon is both teacher and laboratory. Its hidden fungal engineers show that even the most intractable human creations are not beyond life’s capacity for transformation. And if we listen — truly listen — to these quiet tutors, we might finally learn to live in a way that does not merely postpone disaster, but fosters regeneration, resilience, and hope.
References
Agarwal, A., et al. (2024). Solutions for space waste: Biodegradation of polyurethane by Pestalotiopsis microspora in microgravity. International Journal of Science and Research, 14(1). DOI: https://dx.doi.org/10.21275/SR241230151350
Afshar, S. V., Boldrin, A., Astrup, T. F., Daugaard, A. E., & Hartmann, N. B. (2024). Degradation of biodegradable plastics in waste management systems and the open environment: A critical review. Journal of Cleaner Production, 434, 140000. DOI: https://doi.org/10.1016/j.jclepro.2023.140000
Blakemore, E. (2016). Chow down: Plastic-eating fungus. Smithsonian Magazine. https://www.smithsonianmag.com/smart-news/chow-down-plastic-eating-fungus-180958127/
Deng, L., Qiu, X., Su, Q., et al. (2024). Complete genome sequence analysis of Pestalotiopsis microspora, a fungal pathogen causing kiwifruit postharvest rots. BMC Genomics, 25, 839. DOI: https://doi.org/10.1186/s12864-024-10751-y
Escobedo, G., et al. (2023). Bioremediation of Polyurethane in Soil using P. Microspora. Argonne National Laboratory. U. S. Department of Energy. https://www.anl.gov/sites/www/files/2023-06/West%20Aurora%20High%20School%20ESRP%202023.pdf
Martínez, R. (2025). El sorprendente hongo del Amazonas que se alimenta de plásticos y puede ayudar a limpiar el planeta. Meristation. https://as.com/meristation/betech/el-sorprendente-hongo-del-amazonas-que-se-alimenta-de-plasticos-y-puede-ayudar-a-limpiar-el-planeta-n/
Morunga, A. M. (2024). Plastic pollution’s devastating impact on wildlife. Greenpeace Aotearoa. https://www.greenpeace.org/aotearoa/story/plastic-pollutions-devastating-impact-on-wildlife/
Maharachchikumbura, S., Guo, L., Chukeatirote, E., Bahkali, A., & Hyde, K. (2011). Pestalotiopsis—Morphology, phylogeny, biochemistry and diversity. Fungal Diversity 50, 167–187. DOI: https://doi.org/10.1007/s13225-011-0125-x
Micología Agroforestal. (n.d.). Descubriendo el hongo que come el poliestireno: Pestalotiopsis microspora. https://www.micologiaagroforestal.com/descubriendo-el-hongo-que-come-el-poliestireno-pestalotiopsis-microspora/
National Caucus of Environmental Legislators. (n.d.). Plastic pollution. https://ncel.net/issue/plastic-pollution/
Parker, L. (2023). The World's Plastic Pollution Crisis Explained. Education National Geographic. https://education.nationalgeographic.org/resource/worlds-plastic-pollution-crisis-explained/
Pollution Sustainability Directory. (2025). Plastic degradation rates. https://pollution.sustainability-directory.com/term/plastic-degradation-rates/
Radhi, A. B., & Zaaen, A. Y. (2025). Potential of bioremediation for plastic waste: Bacteria and fungi—A review. Journal of University of Anbar for Pure Science, 19(1), 39–57. DOI: https://doi.org/10.37652/juaps.2024.152830.1311
Russell, J. R., et al. (2011). Biodegradation of polyester polyurethane by endophytic fungi. Applied and Environmental Microbiology, 77. DOI: https://doi.org/10.1128/AEM.00521-11
Ritchie, H., Samborska, V., & Roser, M. (2023). Plastic pollution. Our World in Data. https://ourworldindata.org/plastic-pollution
Sharp, R., & Kar, A. (2024). What you need to know about the plastic crisis. NRDC. https://www.nrdc.org/bio/avinash-kar/what-you-need-know-about-plastic-crisis
Smith, A. (2025). Plastic crisis: Lancet report warns trillions needed for global treaty on death, disability, health risks. NBC News. https://www.nbcnews.com/science/science-news/plastic-crisis-lancet-trillions-global-treaty-death-disability-health-rcna222827
United Nations Environment Programme. (n.d.). Plastic pollution. https://www.unep.org/plastic-pollution
Vasarhelyi, K. (2021). Plastic eating mushrooms: a viable solution for plastic decomposition? Colorado University Environmental Center. https://www.colorado.edu/ecenter/2021/11/04/plastic-eating-mushrooms-viable-solution-plastic-decomposition
Yeoman, B. (2019). A Plague of Plastics. National Wildlife Federation. https://www.nwf.org/Magazines/National-Wildlife/2019/June-July/Conservation/Ocean-Plastic